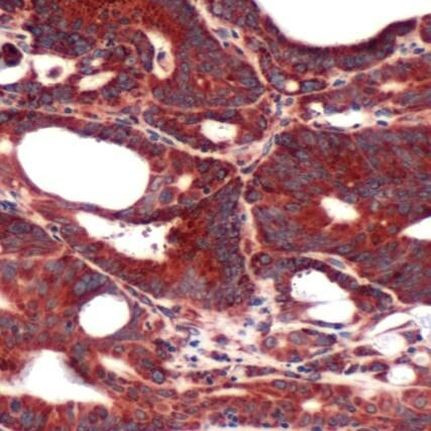
FABP3 Antibody in Immunohistochemistry (IHC)

Search
Invitrogen
FABP3 Polyclonal Antibody
{{$productOrderCtrl.translations['antibody.pdp.commerceCard.promotion.promotions']}}
{{$productOrderCtrl.translations['antibody.pdp.commerceCard.promotion.viewpromo']}}
{{$productOrderCtrl.translations['antibody.pdp.commerceCard.promotion.promocode']}}: {{promo.promoCode}} {{promo.promoTitle}} {{promo.promoDescription}}. {{$productOrderCtrl.translations['antibody.pdp.commerceCard.promotion.learnmore']}}
产品信息
PA5-32487
宿主/亚型
分类
类型
抗原
偶联物
形式
保存条件
运输条件
RRID
产品详细信息
Heat-mediated antigen retrieval is recommended prior to staining, using a 10mM citrate buffer, pH 6.0, for 10 minutes followed by cooling at room temperature for 20 min. Following antigen retrieval, incubate samples with primary antibody for 30 min at room temperature. A suggested positive control is colon carcinoma.
靶标信息
Fatty acid binding proteins (FABP) are small (approximately 13-14 kDa) intracellular proteins with a high degree of tissue specificity. FABPs are a class of cytoplasmic proteins that bind long chain fatty acids. They are abundantly present in various cell types and seem to play an important role in the intracellular utilization of fatty acids. There are at least six distinct types of FABP, each showing a specific pattern of tissue expression. FABP leaks, due to its small size, rapidly out of is chemically damaged dying cells leading to a rise in serum levels. Liver FABP is a sensitive marker for cell damage of liver cells in vitro and in vivo. Is chemically damaged tissues are characterized histologically by absence (or low presence) of FABP facilitating recognition of such areas. Next to this L FABP is a marker for rapid hepatocyte lysis in vitro (as for example in toxicology assays) and for detection of liver damage during and after transplantation.
仅用于科研。不用于诊断过程。未经明确授权不得转售。